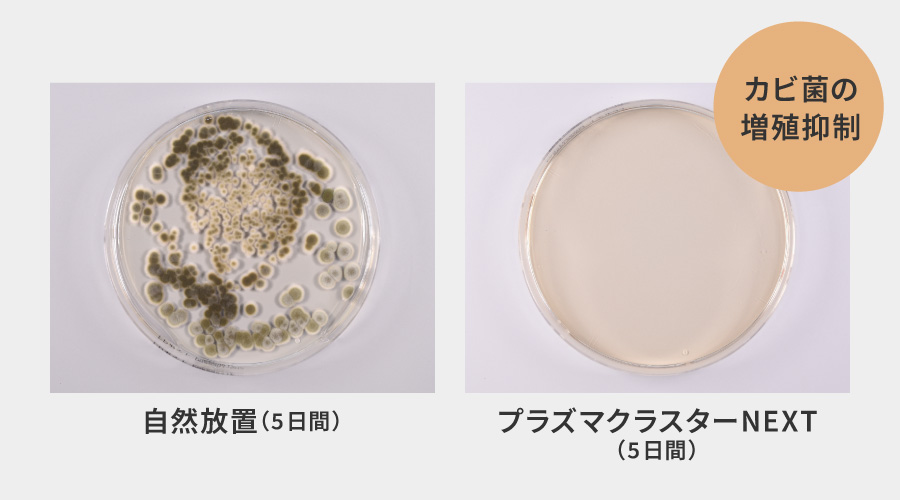
5日間自然放置した場合は付着カビ菌が増殖するが、5日間プラズマクラスターNEXTで除湿した場合は付着カビ菌の増殖を抑制することを示す実験結果画像。

プラズマクラスターNEXT
01プラズマクラスターとは
当社史上最高濃度のプラズマクラスターNEXT搭載
高濃度プラズマクラスターイオンの風は、部屋干しの生乾きのニオイを消臭するなど高い空気浄化力を発揮します。
- 当技術マークのイオン個数の目安は、商品を壁際に置いて、「風量最大」運転時にプラズマクラスター適用床面積の部屋中央(床上1.2m)で1cm³当たり50,000個以上です。
 *
*

<プラズマクラスター技術の紹介>
信頼の証。プラズマクラスターはシャープだけ
森林には+と-のイオンが都市部に比べて多く存在しています。 プラズマクラスターイオンは安全性を確認済みなので、高濃度化が可能。森林よりも多い+と-のイオンがお部屋に広がり、清潔で健やかな空気環境をつくります。

プラズマクラスターのメカニズム
カビ菌や菌などの表面から水素原子(H)を素早く奪い取ることで、その作用を抑制。OHラジカルは奪い取った水素原子(H)と結合し、反応後は速やかに水(H₂O)となって空気中に戻ります。

02主な効果
気になるニオイもしっかり消臭※1*1*2
当社史上最高濃度のプラズマクラスターイオンの風で、部屋干し衣類の生乾き臭をしっかり消臭。*1
■ 部屋干し衣類の生乾き臭比較

付着したニオイを消臭
生乾き臭に加え、ペット臭や、料理臭、たばこ臭などの付着したニオイまで消臭します。
1枚目:部屋干し衣類の生乾き臭、ペット臭、料理臭、タバコ臭、2枚目:汗臭、ミドル脂臭、加齢臭、排泄物臭
吹き出し方向に約1m~約2mの位置で、約20分~約4時間後の効果です。試験空間における実証結果であり、実使用空間での実証結果ではありません。ニオイの種類・強さ・対象物の素材などによって、消臭効果は異なります。吹き出す風の当たらない部分のニオイは取れません。
付着ウイルス・付着菌の作用を抑える*4*5

吹き出し方向に約2mの位置で、約4~約7時間後の効果です。試験空間における実証結果であり、実使用空間での実証結果ではありません。
付着カビ菌の増殖を抑制*6
5日後の効果です。約5畳相当の試験空間における実証結果であり、実使用空間での実証結果ではありません。使用場所の状況や使い方によって効果は異なります。


